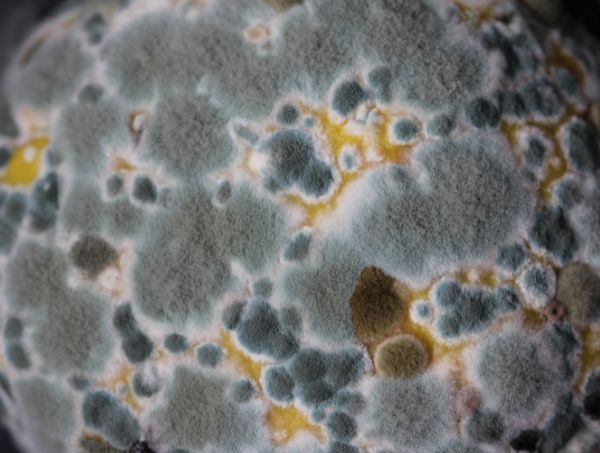
Conseils

Lire plus
Apprendre à cultiver du cannabis n’aura jamais été aussi simple qu’avec les articles du blog de GB The Green Brand. Dans cette section, nous publierons à la fois des conseils pour les débutants et des recommandations pour approfondir les connaissances des plus expérimentés. De plus, vous pourrez y trouver de nouvelles idées pour vos cultures d’intérieur et d’extérieur, ainsi que des indications pour une bonne utilisation des engrais, terreaux et autres produits cannabiques.

Lire plus

Lire plus

Lire plus

Vous ne savez pas la différence entre Indica et Sativa ? On vous explique ...
Lire plus

Lire plus

Faire des boutures de cannabis, la clé pour multiplier vos plantes sans vo...
Lire plus

Lire plus

Lire plus

Question posée par de nombreux cultivateurs et à laquelle nous répondons...
Lire plus

Lire plus

Lire plus

Lire plus

Découvrez les disques de germination Jiffy pour un bouturage irréprochabl...
Lire plus

Obtenez des bourgeons de qualité en faisant sécher votre cannabis.
Lire plus

Lire plus

Lire plus

Lire plus
Lire plus

Lire plus

Lire plus

Lire plus

Lire plus

Lire plus
